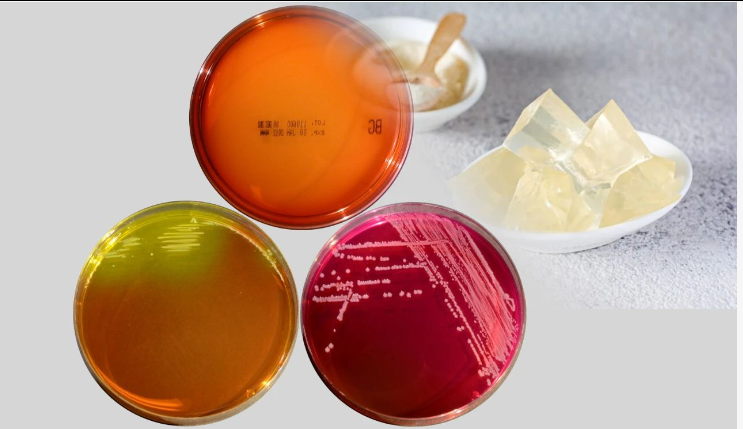

琼脂是什么
琼脂,学名琼胶,英文名(agar),又名洋菜(agar-agar)、海东菜、冻粉、琼胶、石花胶、燕菜精、洋粉、寒天、大菜丝,是植物胶的一种,常用海产的麒麟菜、石花菜、江蓠等制成,为无色、无固定形状的固体,溶于热水。在食品工业中应用广泛,亦常用作细菌培养基。
提炼琼脂的工艺途径
琼脂在微生物培养中的作用
产品信息

产品名称:琼脂粉
CAS:9002-18-0
凝胶强度 :400-1200g/cm2
规格:500g、1Kg、25Kg
凝胶温度(1.5%):32~39℃
熔胶温度(1.5%) :≤85℃
相关产品列表
|
产品名称 |
CAS号 |
凝胶强度 |
产品说明 |
|
琼脂糖 |
9012-36-6 |
≥1200 g/cm2 |
高强度琼脂糖 |
|
琼脂糖 |
9012-36-6 |
≥1500 g/cm2 |
低电渗琼脂糖 |
www.seebio.cn(生物试剂)
www.cxbio.com(科研服务)
www.allinno.com(西宝国际)
点击【在看】
分享给更多需要的人
声明
1、本公众号所发表的内容注明来源的,版权归原出处所有,其观点不能代表本公众号立场。如有侵权请联系编辑微信:13917439331
2、本公众号原创文章,任何媒体、个人、网站如需转载,须在文首位置注明“AI西宝生物”并注明作者。